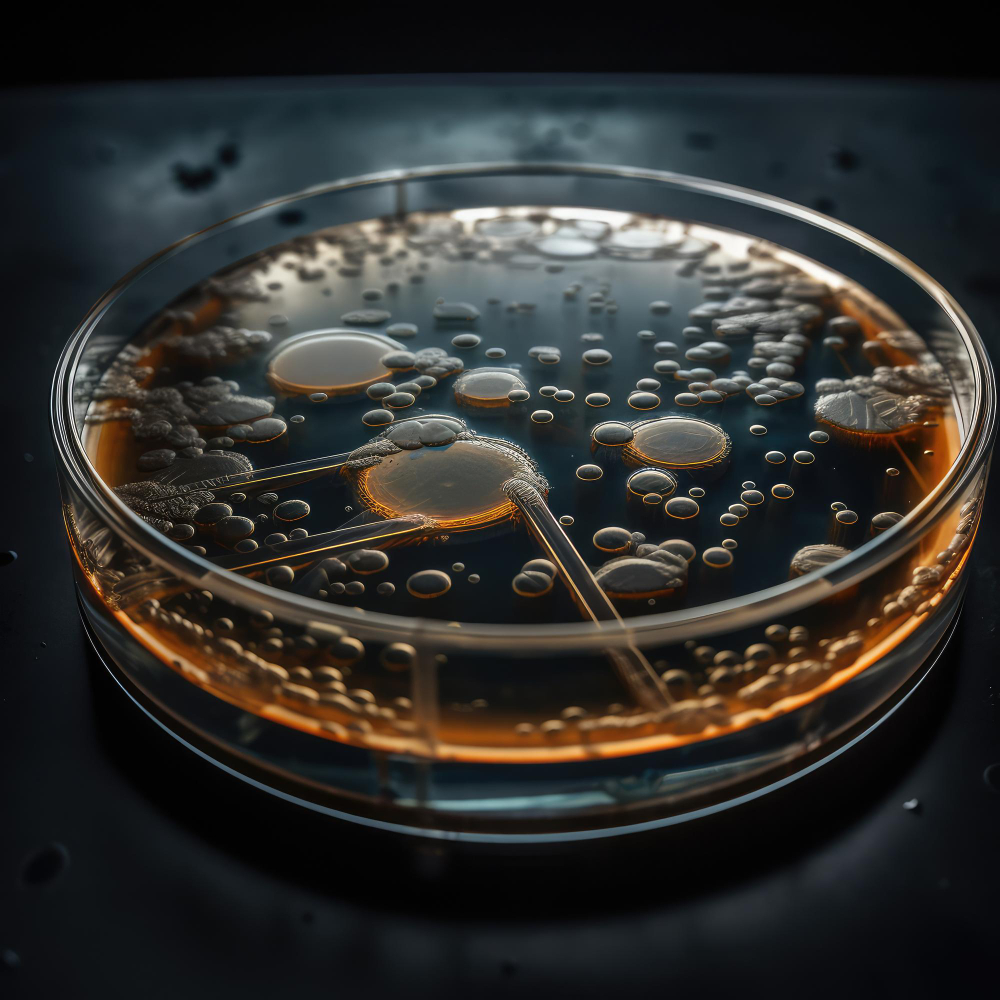

Brewing Solutions

Malts
This is our diverse range of quality kilned malts, crafted from the finest European 2-row spring barley. These malts can be used as the primary ingredient for various types of beers, including Pilsner, Lager, Ale, IPA, Blonde, Tripel, Porter, and Stout. Each product offers unique aromas and colors, yet they share a common purpose – they are the foundation for any beer you wish to brew.
Yeast
When using these yeasts, there is no need to propagate or make starters. They offer a cost effective and convenient alternative to liquid yeast products, and have the advantage of extended shelf life with consistent high performance.
Flavours
Whenever brewers are looking to develop a new beer or introduce a product to compete in the market, our solutions provide fast, efficient, and industry-leading results.
Imagine being able to craft a Belgian-style wheat beer, a fruity brew, or a top-fermentation beer, all while staying focused on your usual brewing process without any extra effort.
Our flavor products consist of exclusively natural ingredients, including:
These elements work together to provide brewers with high-quality, natural solutions for enhancing flavor, color, and appearance.
Some ready products
Classic Beer Styles
Fruit Beers
Cocktail Beer
Non-Alcoholic Beers
We’ve developed a range of natural aromatic combinations, including body enhancers, fermentation flavor notes, and hop notes, designed to elevate non-alcoholic (NA) beers. These solutions address common challenges by adding characteristics typically found in lagers. The hop notes help maintain freshness over time while masking or balancing the wort taste, giving NA beers a more complete and satisfying flavor profile.
There are various methods to produce non-alcoholic and low-alcohol beers (NABLABs), such as minimizing fermentable sugars, using special yeasts, or eliminating alcohol through techniques like reverse osmosis or vacuum distillation. However, many NA beers on the market still fall short, often tasting too watery or lacking fermentation character.
To address this, we’ve developed over 10 natural aromatic solutions, to enhance NA beers. These products improve body, mask wort flavors, add hop notes, and impart lager fermentation characteristics. Additionally, it reduces watery sensation and improves flavor, and hop notes to mask wort taste. It also helps to maintain freshness over time.
We also offer customized solutions, which adjusts pH and balances flavors in diluted wort. Our range enables brewers to create various craft beer styles, from lagers to IPAs, directly from an NA base or wort, all tailored to the brewer’s specific needs.
Brewing enzymes
Brewing enzymes are specialized proteins that enhance the brewing process by breaking down complex sugars and other compounds in grains. They play a crucial role in converting starches into fermentable sugars, improving the efficiency and flavor of the final product. Additionally, these enzymes can help in clarifying the brew and optimizing the overall fermentation process.
Process Solution
Process solutions focus on optimizing fermentation and brewing efficiency. This includes the use of specialized enzymes to enhance starch conversion, improve filtration, and control haze stability. By integrating automation and data analytics, breweries can monitor and adjust conditions in real-time, ensuring consistent quality and reducing production costs.
Crafted for Brewers, Perfected for Beer Lovers
Crafted for Brewers, Perfected for Beer Lovers" captures our philosophy of creating innovative, high-quality brewing solutions that meet the needs of brewers while delivering exceptional beer experiences for consumers.
© 2024 Copyright Brewwise Solutions